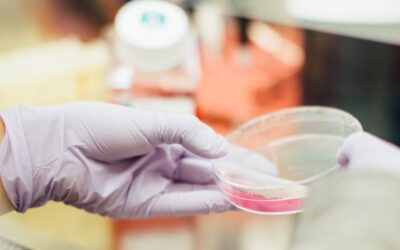
UK law for stored eggs, sperm or embryos

Knowledge Centre
Surrogacy law for different-sex parents
There are many reasons why you may need the help of a surrogate to carry your child as a heterosexual (different-sex) couple. You may have medical issues or a fertility history which means that you cannot carry a pregnancy, or one of you may be transgender....
Surrogacy law for same-sex parents
If you are gay dads (a male same-sex couple), surrogacy is a way of conceiving a child who is biologically connected with you, and who will be part of your family immediately from birth. Surrogacy is rarer for lesbian mums (female same-sex couples) unless one or both...
Surrogacy law for single parents
Surrogacy is a way of building a family for both single mums and single dads. For single dads, it may be your main path to conceiving a biological child who will be part of your family from birth. For single mums, there are a range of possible reasons why you may...
Surrogacy law for surrogates
Carrying a pregnancy for someone who cannot do so themselves is an incredible thing to do. Surrogacy is legal in the UK and, if you follow the right legal process, you will no longer be a legal parent of the child you give birth to. As experienced UK surrogacy...
Donor conception and co-parenting law for same-sex parents
Female same-sex parents conceive children together in different ways including: through sperm donation at UK fertility clinics, through sperm donation at overseas fertility clinics, with the help of someone they already know (either conceiving at a fertility clinic or...
Donor conception law for different-sex parents
This guide steers you through the UK legal issues if you are a different-sex couple and need the help of an egg, sperm or embryo donor to create your family. How does the law regulate gamete and embryo donation in the UK? If you conceive at a fertility clinic in the...
Donor conception and co-parenting law for solo mothers
Single or ‘solo’ mothers conceive children in different ways including: through egg, sperm or embryo donation at UK fertility clinics, through egg, sperm or embryo donation at overseas fertility clinics, with the help of someone they already know (either conceiving at...
Donor conception and co-parenting law for egg, sperm and embryo donors
Donating your eggs, sperm or embryos to someone else to help them conceive a child is an incredible thing to do. This guide steers you through what you need to know about UK law. How does UK law work if I donate through a licensed fertility clinic? If you donate...
Transgender parents conceiving children
Updated February 2026. Parents who are transgender, non-binary or gender diverse conceive children in a range of different ways. You may be able to conceive without medical intervention if one partner can carry a pregnancy and the other can provide sperm....
International surrogacy (UK law)
It is increasingly common for intended parents to cross borders for surrogacy, to build their families in ways which are impossible or impractical to achieve at home. There is no international framework for regulating surrogacy services, or the recognition of legal...
Surrogacy in the UK (UK law)
It is, and always has been, legal to enter into a surrogacy arrangement in the UK. However, the legal framework established by the Surrogacy Arrangements Act 1985 does not always make things easy. As specialist surrogacy lawyers, we have created this guide to help you...
Parental orders (surrogacy law)
The UK legal solution designed for resolving parenthood in surrogacy cases is a parental order. This is a post-birth court order which can be made by the family court to make the intended parent/s the legal parents of the child and to permanently extinguish the legal...
Legal rights in the post-birth period (surrogacy)
Since UK law does not recognise the intended parents as the legal parents of their child from birth, there is a period of time during which the family is in legal limbo, even though the parents assume care of their child immediately from birth. The Department of...
Surrogacy disputes in UK law
Intended parents considering surrogacy often worry about surrogacy agreements not being binding, and fear what might happen if the surrogate does not hand over the baby at birth. Equally many surrogates fear that the intended parents will not assume responsibility...
UK surrogacy law: history and reform
The UK's surrogacy laws were written more than thirty years ago and are woefully out of date and out of step with modern understanding of families. Under the current law: The surrogate and her spouse are the legal parents of the baby born Surrogacy agreements are...
Donor conception at UK fertility clinics (UK law)
The Human Fertilisation and Embryology Authority regulates fertility treatment with donor eggs, sperm or embryos in the UK. Anyone who collects, stores or uses human gametes or embryos in the UK must have an HFEA licence and must comply with the HFEA's Code of...
Known donation arrangements (UK law)
Known donation arrangements cover a wide range of different personal circumstances. In some cases a known egg, sperm or embryo donor is a relative, friend or someone else already known to the recipient/s. In other cases the donor is someone the recipients have...
Legal parenthood after donor conception and assisted reproduction
Where children are conceived through artificial insemination or the transfer of an embryo, the Human Fertilisation and Embryology Act 2008 dictates who the legal parents will be. The rules are broadly designed to protect the status of parents who conceive through...
Co-parenting arrangements and multi-parent families
Parents who are not in a relationship with each other but each want a family may agree to conceive a child together as co-parents. If both are single, your child will typically have a mother and a father, but if either of you is in a relationship then your child may...
UK law for stored eggs, sperm or embryos
The Human Fertilisation and Embryology Authority (HFEA) was set up in 1991 and comprises members who are clinicians, researchers or fertility/embryology professionals and a lay chair. The Authority oversees a staff which runs a licensing system for anyone who provides...
Legal parenthood where a child is born after their parent has died
Where a child is born after their parent has died, there can be complex questions about whether the deceased parent is a legal parent, and what can be recorded on the child’s birth certificate. Where a parent dies during pregnancy Legal parenthood crystallises at the...
Recognition of overseas adoptions in UK law
The law governing how overseas adoptions are recognised in the UK is complex. If you have created your family through adoption abroad and are British or plan to live in the UK, then you may want to know whether you are recognised as a family under UK law, and whether...
Using adoption to secure your family’s status
Adoption can be a useful way of securing your status as a parent of a child who is already part of your family if you are not otherwise recognised as his or her legal parent. This might be because: You are a step-parent – your child was conceived in a previous...
Securing parental rights in ways other than adoption
Although under UK law a child can only have two legal parents, there is no limit on how many people can share parental responsibility. Parental responsibility gives you the right to make and be involved in decisions about your child's care, including decisions as to...
Legal guides: Surrogacy by destination

UK surrogacy

USA surrogacy

Ukraine/ Georgia surrogacy

Canada surrogacy

South America surrogacy

Europe surrogacy

Africa surrogacy

Asia surrogacy
The Brilliant Beginnings Surrogacy Knowledge Centre
Brilliant Beginnings, is a non-profit surrogacy agency, founded by the NGA Law directors in 2013.
Their Knowledge Centre includes practical guidance and resources on surrogacy in the UK and USA.
Still have questions?
If you need legal advice or want to make an appointment, feel free to get in touch. We offer meetings in-person in London or in the New Forest, as well as online.
We are here to help however we can.